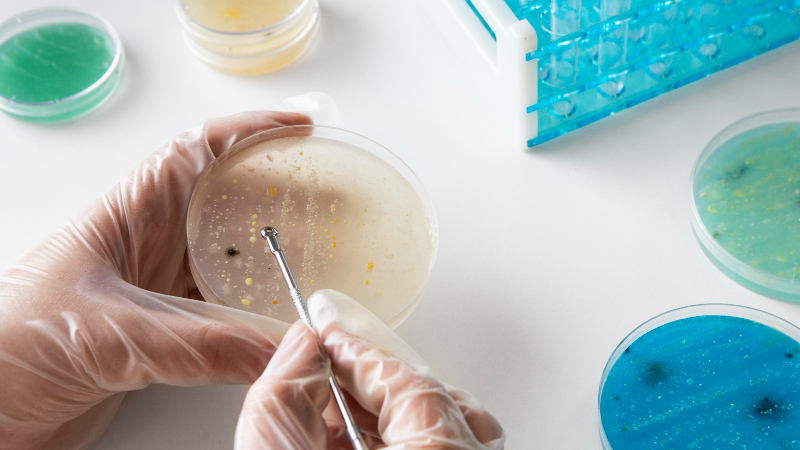

Em 22/09 acaba o período de inscrição (imagem: Freepik)
Candidatos devem ser graduados nas áreas de ciências biológicas ou ciências da saúde, sem reprovações no histórico escolar e, de preferência, com alguma experiência em prática de laboratório
Candidatos devem ser graduados nas áreas de ciências biológicas ou ciências da saúde, sem reprovações no histórico escolar e, de preferência, com alguma experiência em prática de laboratório
Em 22/09 acaba o período de inscrição (imagem: Freepik)
Agência FAPESP – O projeto “Análise genômica, transcriptômica e caracterização fenotípica de linhagens de Campylobacter jejuni isoladas de diferentes fontes no Brasil” oferece uma oportunidade para treinamento técnico nível três (TT-3) com bolsa da FAPESP. As inscrições encerram-se em 22 de setembro.
O projeto é conduzido na Faculdade de Ciências Farmacêuticas de Ribeirão Preto da Universidade de São Paulo (FCFRP-USP).
Os candidatos devem ser graduados nas áreas de ciências biológicas ou ciências da saúde, sem reprovações no histórico escolar e, de preferência, com alguma experiência em laboratório de microbiologia.
Mais informações sobre a vaga e as inscrições em: www.fapesp.br/oportunidades/8535/.
A Bolsa de TT-3 tem valor de R$ 1.800,00 mensais para dedicação de 40 semanais e de R$ 855 para dedicação de 20 horas semanais. É direcionada a graduados do nível superior, sem reprovações no histórico escolar. A dedicação deverá ser de 16 a 40 horas semanais às atividades de apoio ao projeto de pesquisa.
Mais informações sobre as bolsas de Treinamento Técnico da FAPESP: www.fapesp.br/bolsas/tt.
Outras vagas de bolsas, em diversas áreas do conhecimento, estão no site FAPESP-Oportunidades, em www.fapesp.br/oportunidades.
Republicar
A Agência FAPESP licencia notícias via Creative Commons (CC-BY-NC-ND) para que possam ser republicadas gratuitamente e de forma simples por outros veículos digitais ou impressos. A Agência FAPESP deve ser creditada como a fonte do conteúdo que está sendo republicado e o nome do repórter (quando houver) deve ser atribuído. O uso do botão HMTL abaixo permite o atendimento a essas normas, detalhadas na Política de Republicação Digital FAPESP.





